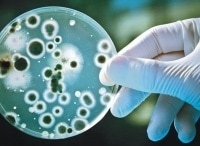
Вторжение-микробов

Программа ТВ →
ТВ Центр (ТВЦ) →
Вторжение микробов
Вторжение микробов
Вторжение микробов смотрите 15.05.2011 в 00:00 на телеканале ТВ Центр (ТВЦ)
В нашей жизни присутствуют миллиарды микробов. Некоторые из них - наши союзники, а некоторые - враги. Поставив себе на службу полезные бактерии, человечество сможет решить множество проблем.
Что посмотреть еще?Отзывы и рецензии зрителей
Здесь Вы не сможете добавить свой комментарий, но в ближайшем будущем все будет...
|




